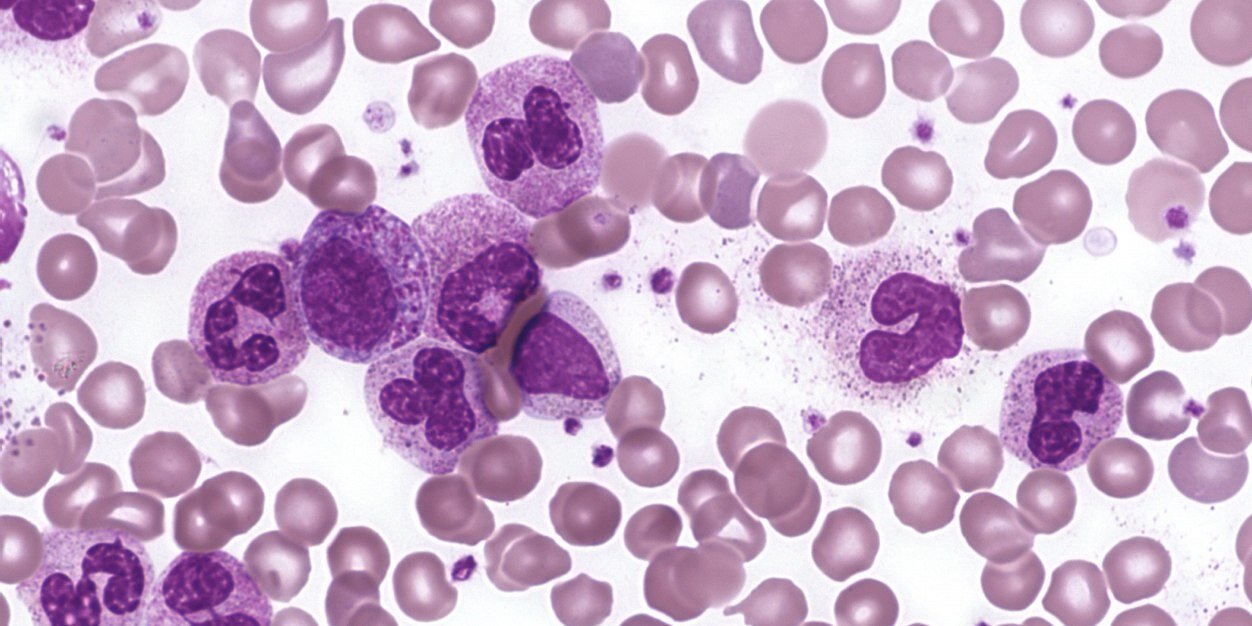
Adam Forman, MD 🩸 banner

Adam Forman, MD 🩸
1.6K posts

Adam Forman, MD 🩸
@FormanAM
just a simple country doctor

I am incredibly proud of Isra and everyone who made the trip to Cuba. They took tons of aid to make sure the people of Cuba knew that there are so many people across the world who stand in solidarity with them. Cuba has always sent aid to countries in need and has trained thousands of physicians across the world, including my childhood physician. @israhirsi is more than just my daughter, she is a brilliant young leader who has always worked hard to advocate for a more just world. She inspires me and so many people with her leadership and dedication. I am forever fortunate to have her as my daughter but I am even more fortunate to know her as the unflinching justice warrior for justice she is. #letcubalive

Today the gestapo is in the airports. Next it’ll be polling places. Stand up. Don’t normalize this.

Chicago Alderwoman Maria Hadden: Sheridan (18) was in "wrong place at the wrong time — she might've startled the migrant who kiIIed her"


I'm an American trauma surgeon. One year ago today I was volunteering at Nasser Medical Complex in Gaza when Israel fired a missile into the room of my 16-year-old patient, Ibrahim Barhoum. The missile killed him instantly. If it had hit the room 90 seconds later it would have killed me, too. Today the US and Israel are still blocking medical supplies from entering Gaza, and are repeating the assault on hospitals and healthcare workers across Lebanon. This is nothing but barbarism. It must be stopped.

“British Muslims are scared,” says Sadiq Khan - after FOUR Jewish communities had their voluntary ambulance services torched 🇬🇧






It's astonishing that the Democratic Party is so committed to dying on the hill of protecting illegal immigration that they're willing to subject people to this

This is the only thing you need to know. Democrats want to open TSA. Republicans are refusing because they want to attach ICE funding. That’s why there are long lines. ICE.


UC Berkeley has settled a Zionist organization’s lawsuit by agreeing to instruct students, faculty and staff on the dangers of antisemitism and to pay $1 million to cover the group’s legal fees. sfchronicle.com/politics/artic…

Pay attention to Lebanon. Trump and Netanyahu started a regional war in the Middle East, creating a humanitarian disaster. And now, the Israeli army has killed over 1,000 people in Lebanon—about 20% of them are kids. Congress should not bankroll this escalating war of choice.











